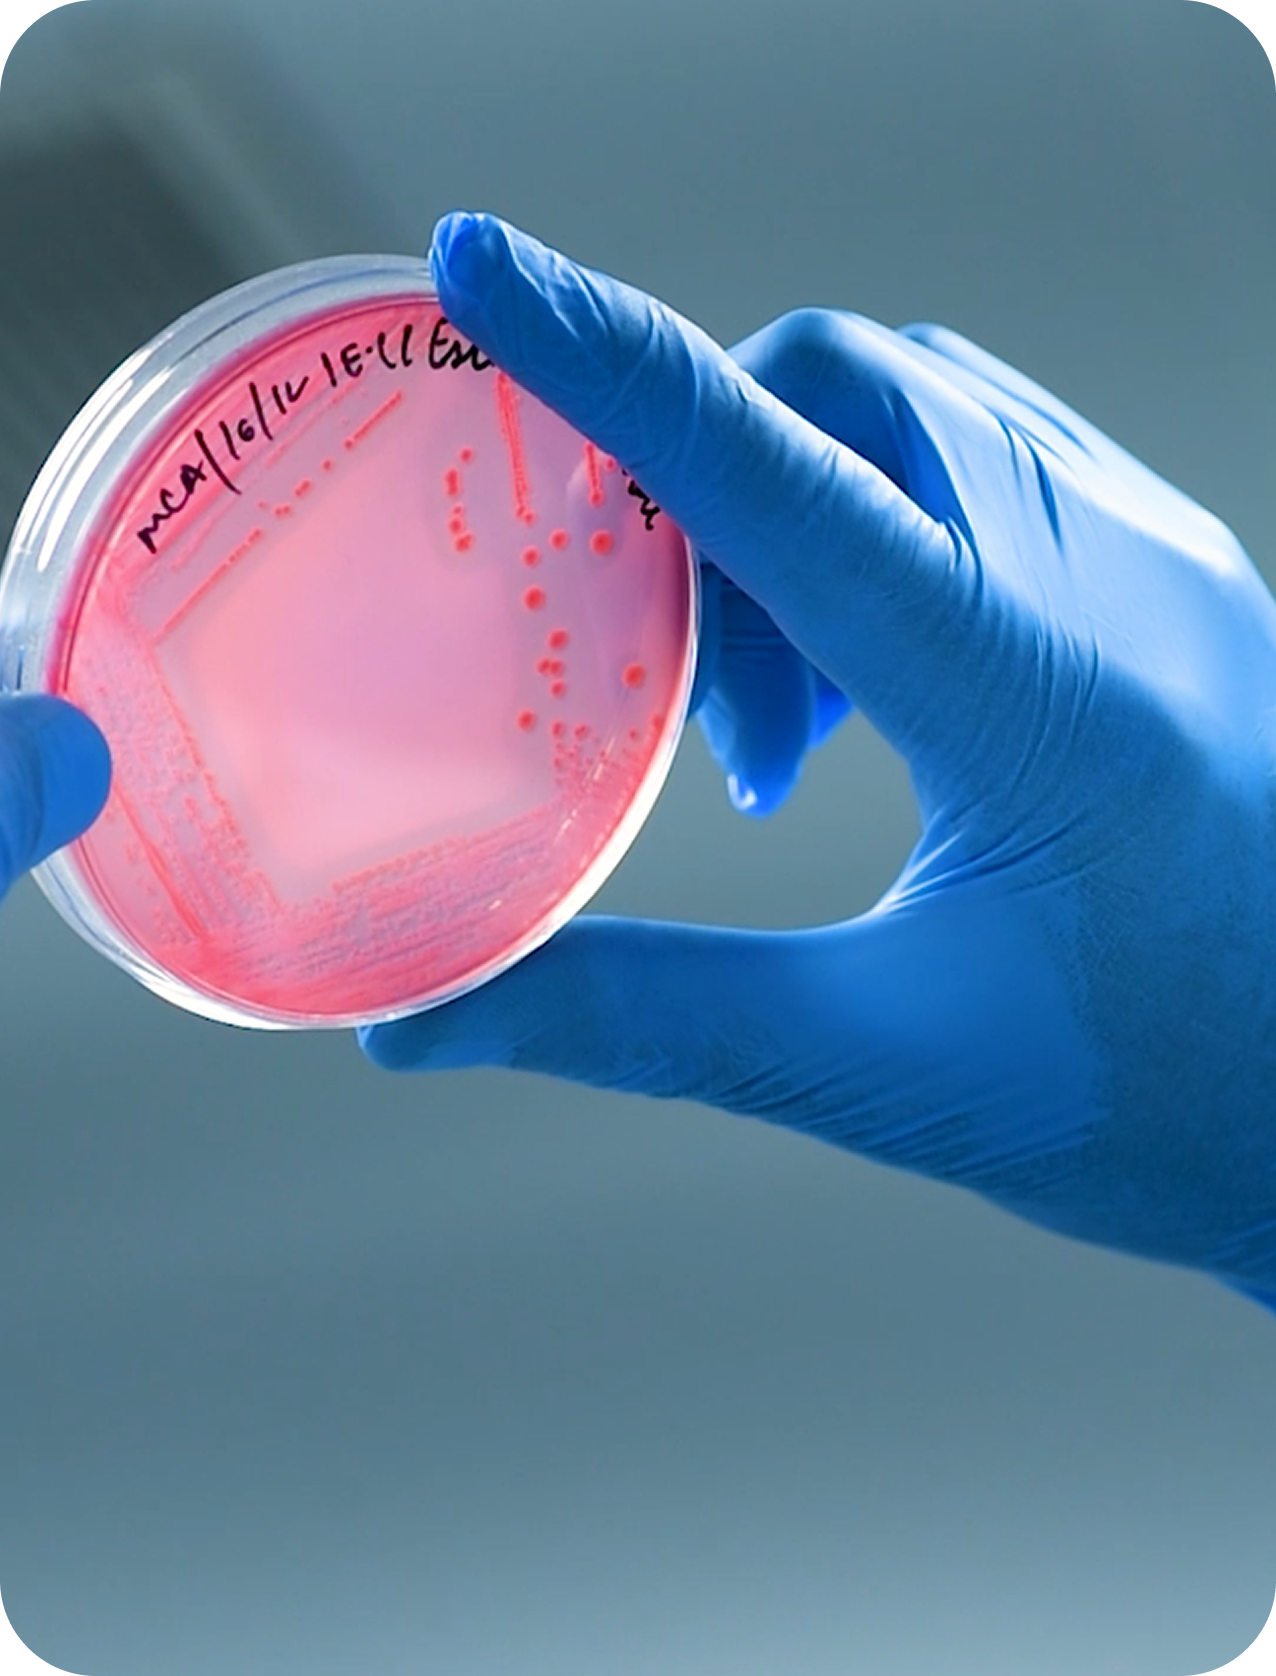

True purity cannot be manufactured, it can only be protected, preserved, and passed on with care.
At Cultivator, production is not just a process, it is a promise. From seed to blend, every step carries the earth’s heartbeat and the sacred trust of generations. Our role is not merely to manufacture, but to honor nature’s gifts by preserving their integrity at every step.
Powered by renewable energy and guided by globally recognized certifications, our facilities bring together the traditional wisdom and the precision of modern science. Within pharmaceutical-grade cleanrooms, under strict hygiene and safety protocols, every product is crafted with devotion, ensuring it reaches you as pure as nature intended.

Images of our facilities
UNIT 1
UNIT 2
UNIT 3
Head office & R&D Hub

Cleanroom Processing & Finished Goods





Raw Material Processing & World-Class Warehouse












